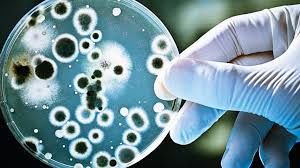

Jazida com mais de 1.000 toneladas de ouro é descoberta por geólogos
A descoberta de um potencial depósito gigantesco de ouro sob o campo aurífero de Wangu, na província de Hunan, na China, desperta interesse e promessas de transformações econômicas na região. Com uma estimativa inicial de mais de 1.000 toneladas métricas de ouro, sendo 300 toneladas já confirmadas próximas à superfície, a expectativa de valor total...
The post Jazida com mais de 1.000 toneladas de ouro é descoberta por geólogos appeared first on O Antagonista.
Fonte original: abrir